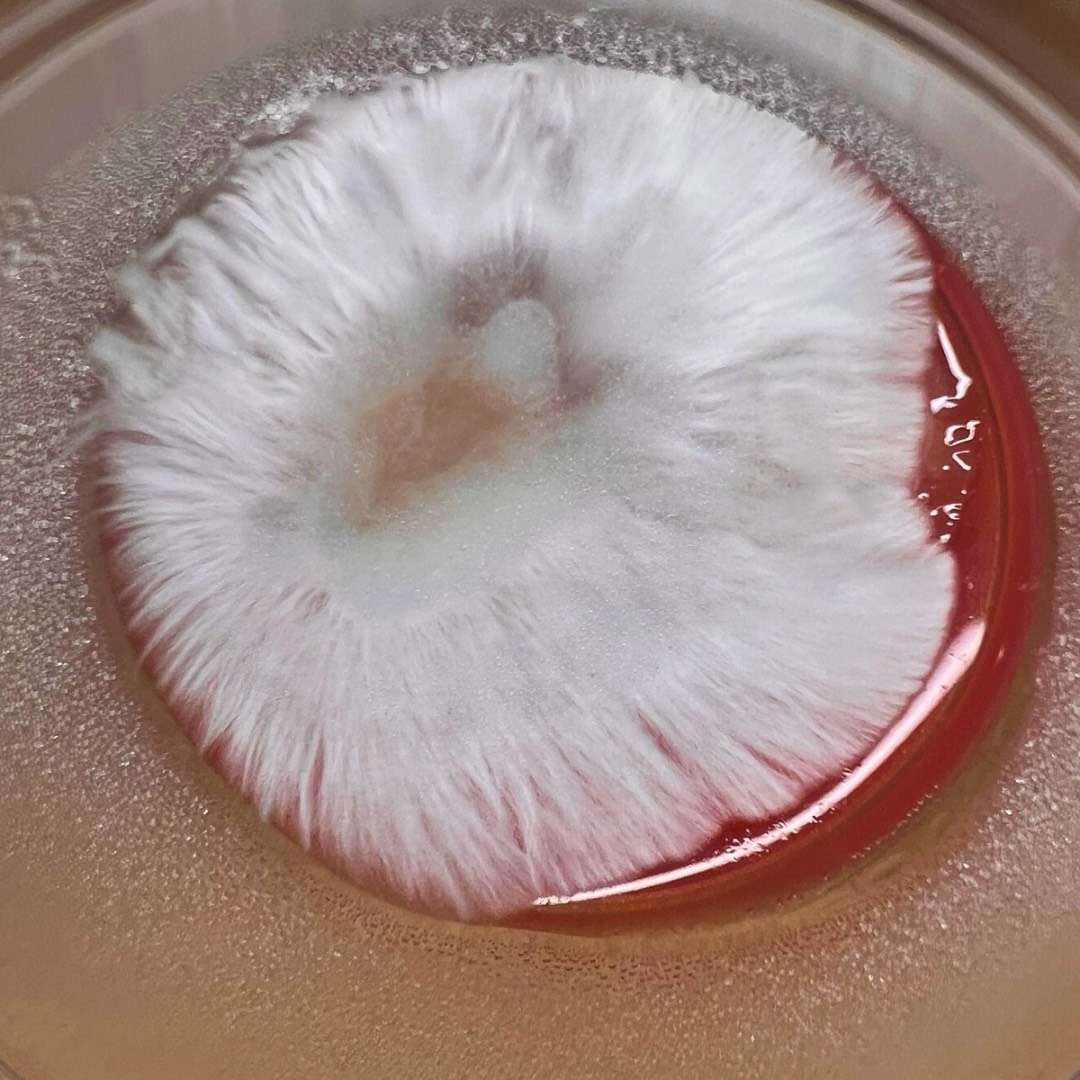

When people think of ‘genetics’, they often picture white lab coats and million-dollar facilities. My mushroom genetics lab doesn’t look like that. It looks like countertops stacked with agar plates, cabinets filled with jars, and magnetic stir plates humming in the kitchen where my dishes should be. I’ve turned my whole house into a workspace. Not because I planned to, but because mushrooms demanded it.
I’ve been working this way for years, building crosses, isolating traits, and preserving tissue. What I’ve learned is simple: you don’t need a million-dollar setup to change the future. You need curiosity, consistency, and the patience to keep transferring, watching, and waiting until the mycelium shows you something new.
For me, this isn’t about aesthetics. It’s about benefits. Just like doctors once mixed and matched prescriptions, I mix and match mushroom genetics—but instead of side effects and lab tests, my results are clarity, calmness, and potential.
I truly believe that more and more people like me, and more people just looking to improve their health and wellbeing, will be turning to mushrooms in the near future if they aren’t already. Nature overrides what pharmaceuticals pretend to offer, healing at the root, not masking the symptoms.
The First Door That Opened
Golden Teacher was the first psychedelic mushroom I ever tried. It’s the strain that cracked everything open for me. Lighthearted, emotional, fun, and enlightening all at once. It wasn’t just a trip, it was a calling. That one experience showed me this was more than curiosity. This was the work I wanted to dedicate my life to.
From there, I began crossing strains not for looks, but for what they could do. Golden Teacher crossed with Blue Meanie became Golden Meanie—blending the accessibility of one with the potency of the other. Later, Albino Penis Envy and Enigma produced Echo of Envy, a brainlike mutant that people said couldn’t even exist as a stable line. It grew out of the lineage that produced Enigma—which took first place at the 2022 Psilocybin Cup—proving that what grows on my counter can compete with the world’s best.
None of this was by the book. My 150+ transfers of Echo of Envy weren’t a mistake; they were my way of stabilizing, refining, and watching every flush, every tissue sample, every spore print until consistency emerged. Professional mycologists might shake their heads at my methods. I say I’m writing my own book.

Watching Growth in Slow Motion
There’s nothing like that moment when fresh mycelium hits a new agar plate. It’s like an explosion in slow motion, branching out in rhizomorphic patterns, pushing into new nutrients, showing you its strength with every millimeter of growth. That’s meditation for me. That’s therapy.
Each transfer feels like breathing room for the culture, and for me, too. I’ve lived with bipolar disorder, ADHD, and dyslexia since I was five. Consistency has always been the hardest thing to hold on to. But when I sit down with my plates and watch the genetics expand, I feel that consistency in real time. The mycelium teaches patience. It teaches persistence. And it shows me that growth doesn’t need perfection—it needs conditions.
Genetic Variance for Specific Goals
Mushrooms are already proving themselves in ways pharmaceuticals only dream of. Lion’s Mane supports brain health. Reishi strengthens immunity. Cordyceps boosts energy. Turkey Tail fights infections. Chaga protects the body. And that’s before you even get into psychedelics.
Psychedelics are changing medicine right now. Studies show psilocybin can relieve depression, ease anxiety in terminal patients, and help people with PTSD find stability. What I know firsthand is that they can do something even more important: they can give people their lives back.
I’ve lived in both worlds. I grew up on prescriptions—lithium, Remeron, Lamictal, amantadine—a chemical cocktail that left me fogged out and dependent on bloodwork every two weeks just to make sure I wasn’t dying from the medicine that was supposed to keep me alive. Mushrooms flipped that script. They gave me balance without destroying my thyroid. They gave me focus without wrecking my sleep. They gave me healing without side effects.
When I cross strains, I’m not chasing novelty. I’m chasing that future, where instead of mixing pills in a pharmacy, we mix genetics in a dish. Where instead of saying “side effects may include,” we say “benefits may multiply.”
I often explain it like dessert. Mint chocolate chip ice cream is good. Add chocolate syrup, it’s better. Add sprinkles, whipped cream, a cherry, and nuts—now it’s a masterpiece. That’s what crossing strains feels like. Golden Teacher brings approachability. Blue Meanie adds intensity. Enigma brings mutation and depth. Albino Penis Envy stacks on raw potency. Each one layers onto the other, and suddenly you’re not just eating ice cream—you’re tasting possibility.
That’s the treasure map I see spread across my counter every day. A map of potential waiting to be followed.
Building Community Out of Spores and Stories
This work isn’t just mine anymore. It’s grown into a community that spans from Florida to Slovenia and beyond. I hear from people with early dementia who regained focus through mushrooms. Veterans with PTSD who finally slept. Students who check in weekly—sometimes with cultivation questions, sometimes just because they need someone to listen.
That’s the real power of this work: connection. Every time I teach a class, show up at an event, or post on Patreon, I meet people who remind me of myself: people who were out of options until mushrooms gave them another path.
What I’ve learned is that mushrooms don’t just heal the individual. They build bonds. They create networks. They remind us that none of us is alone, even in our hardest struggles. That’s why psychedelics are reshaping mental health care.
I don’t follow the rules because the rules weren’t written for me. I didn’t learn from a textbook. I learned from the agar on my counter, from mistakes that turned into breakthroughs, from mutants that weren’t supposed to stabilize but did.
My house doesn’t look like a lab. But that’s the point. You don’t need millions of dollars to change the world. You need curiosity, patience, and the courage to keep going even when your first 150 transfers look like failures.
That’s why I built Fullsend Organicks. Not to build a brand, but to build proof. Proof that this is possible, proof that consistency can be found, proof that growth doesn’t require perfection—only persistence.
The Future Is Already Here
Mushrooms can break down trash, clean oil spills, and save forests. Psychedelics can help a dying patient face death without fear. They can lift someone with bipolar disorder out of the fog without blood tests, prescriptions, or organ damage. They can give kids with ADHD the calm and focus that no stimulant has ever managed. When you add mushrooms to your life, you’re adding something clean, ancient, and natural…. something built to work with us, not against us.
That’s why I believe the future of medicine isn’t being written in pharmaceutical labs. It’s being written in mycelium. On kitchen counters. In jars and agar plates. In communities where people are tired of side effects and ready for real solutions.
If you take one thing from this, let it be this: mushrooms don’t just grow in dark places—they thrive there. So can you.
Whether you’re facing trauma, mental health struggles, or just looking for a way to reconnect with yourself, know that you’re not alone. There’s a whole community out here walking this path too. And Mother Nature has already given us the tools.
The future of medicine isn’t about creating something artificial. It’s about remembering what’s already here, and finally trusting it enough to grow.
This article is from an external, unpaid contributor. It does not represent High Times’ reporting and has not been edited for content or accuracy.